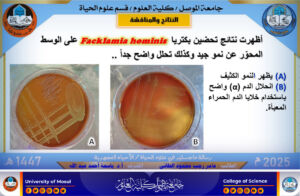

14 September، 2025
Master’s thesis reveals the first recording of Facklamia hominis bacteria in Iraq

On Sunday, September 14, 2025, the Department of Biology at the College of science at the University of Mosul discussed the master’s thesis tagged ” The response of positive atypical bacteria isolated from clinical sources in Mosul / Iraq”, by student Amer Rajab Mahmoud from the microbiology branch.
The discussion was attended by the dean of the College of Science, Prof. Dr. Hiyam Adel Ibrahim, her assistants for scientific and administrative affairs, the head of the department, and a number of college teachers.
The study dealt with the investigation, isolation and diagnosis of Gram-positive atypical bacteria from clinical samples in Mosul, using biochemical tests and molecular techniques. It also included the manufacture of a locally concentrated medium for the first time, and the use of canned blood corpuscles (packaged RBCs) that helped to show the decomposition zones of the “alpha”type.
The most notable results of the research include:
- Diagnose isolates of Facklamia hominis using a heat map, create an evolutionary tree and compare it with global isolates.
- Adopting the Vitek-2 device in diagnostics and matching its results with molecular results.
- Test the sensitivity of isolates to antibiotics and plant extracts (pomegranate peels, propolis, cinnamon, bitter, grape seeds), evaluate their effectiveness in comparison with antibiotics.
This research is the first discovery and registration of these bacteria from clinical samples in Iraq, where the detected strains have been officially approved within the database of the National Center for Life Technologies information (NCBI) under access numbers:
PV719694.1، PV719695.1، PV719696.1، PV719697.1.
The themes of this study are also in line with the Sustainable Development Goals through:
- The third goal (good health and well-being).
- The ninth goal (industry, innovation and infrastructure) .
- The fifteenth goal (life on land) .
The discussion Committee was chaired by Prof. Dr. Esra Ghanem Hazem, and the membership of:
Assistant prof. Dr. Anmar Ahmed Dawood .
Assistant prof. Angham Jabbar Alwan .
Under the supervision and membership of the experienced prof. Dr. Basma Ahmed Abdullah.
We wish our dear students continued success and success in their scientific and research career.
Information and Government Communication Division
Sunday, September 14, 2025